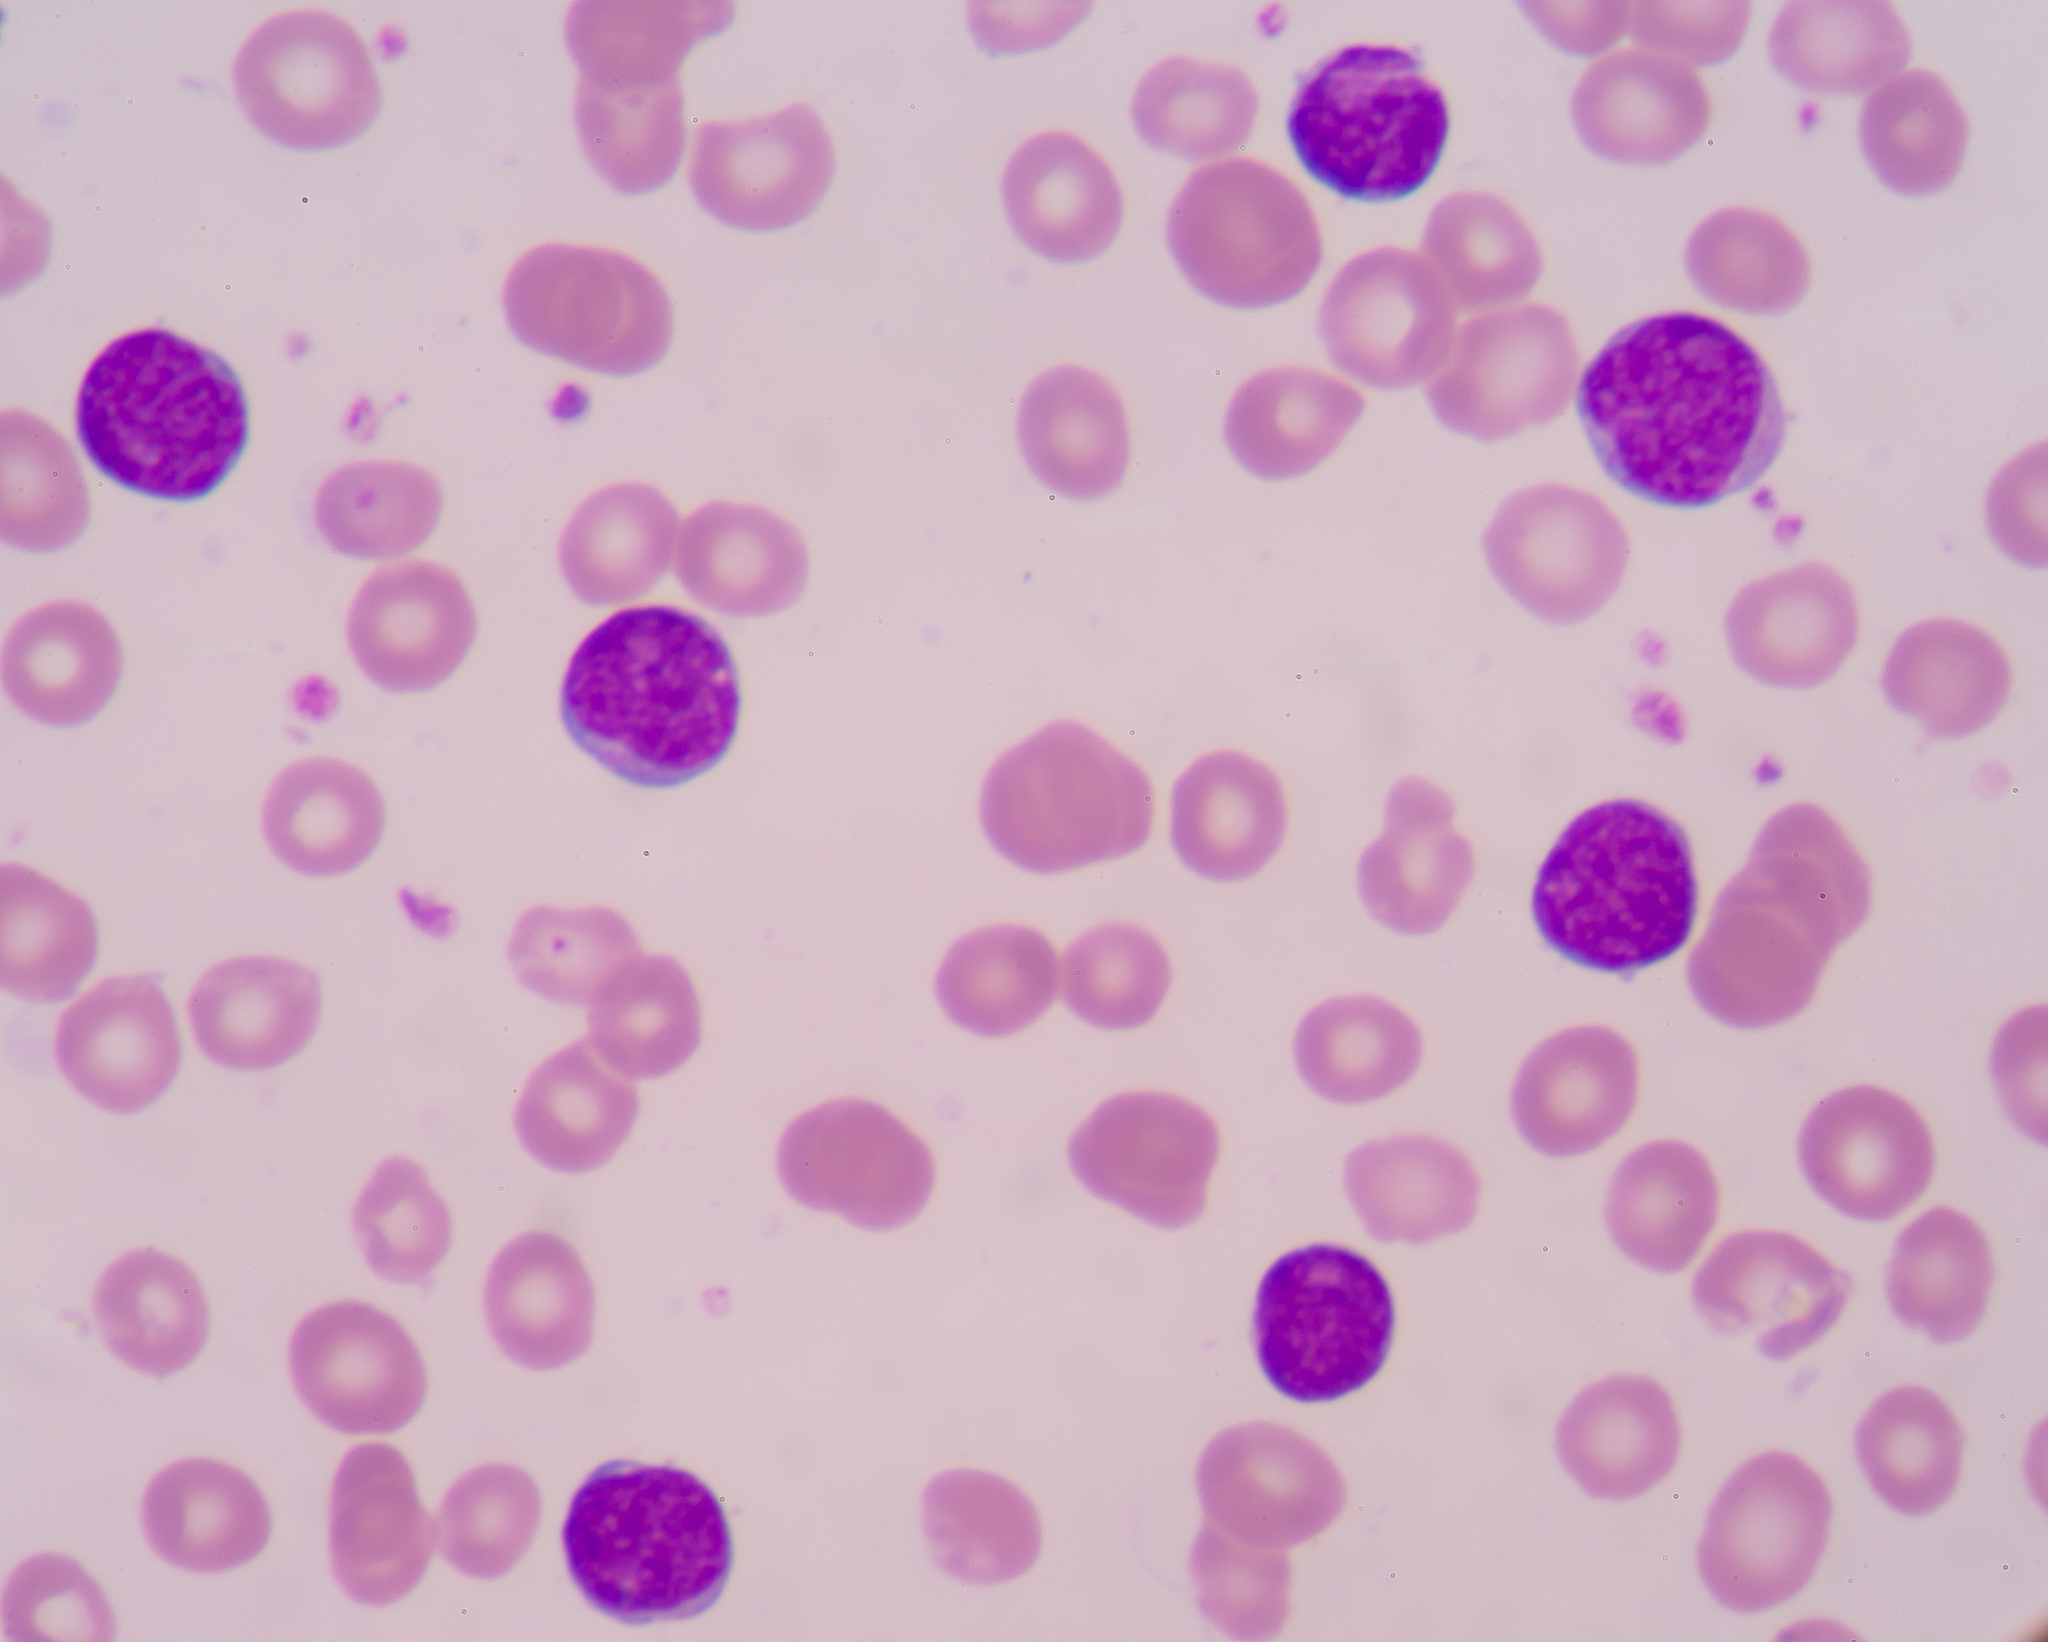
WBC 白细胞计数 1313 109L 35-95 WBC 白细胞计数 1313 109L 35-95

WBC 白细胞计数 1313 109L 35-95
该患者的白细胞计数为13.13 109/L,高于正常范围3.5-9.5。这可能表示患者正在经历一种炎症或感染,并且他们的免疫系统正在积极地对抗它。其他可能的原因包括应激反应、药物反应或白血病等疾病。需要结合其他临床表现和检查结果进行综合分析。

原文地址: https://www.cveoy.top/t/topic/bZwf 著作权归作者所有。请勿转载和采集!
安全问答是一个知识全球问答,包含丰富的问答知识
该患者的白细胞计数为13.13 109/L,高于正常范围3.5-9.5。这可能表示患者正在经历一种炎症或感染,并且他们的免疫系统正在积极地对抗它。其他可能的原因包括应激反应、药物反应或白血病等疾病。需要结合其他临床表现和检查结果进行综合分析。
原文地址: https://www.cveoy.top/t/topic/bZwf 著作权归作者所有。请勿转载和采集!